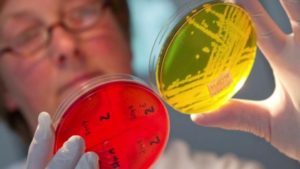

Энтеробиоз очень распространен, поэтому каждый взрослый человек обязан знать, каким должно быть лечение энтеробиоза у взрослых и у детей.
В медицине энтеробиозом называют заболевание, которое возникает впоследствии заражения человека глистами остриц. Острицы — это паразитарные организмы, которые могут спокойно и продолжительно жить только в человеческом кишечнике. В любых других органах они выживают редко, из-за недостачи питательных веществ. Заразиться этими глистами могут как дети, так и взрослые.
Содержание
Как избежать необходимость лечения?
Если в доме был обнаружен хотя бы один зараженный человек, то все члены семьи, проживающие под одной крышей, должны пройти полный курс диагностики. Дабы избежать нежелательных заражений, следует:
- Соблюдать правила личной гигиены, которая заключается в интимной гигиене 2 раза в день и в мытье рук после туалета, перед едой и по приходе домой с улицы.
- Менять белье несколько раз за сутки и спать в плотно прилегающих трусах.
- Постельное белье и одежду следует стирать при температуре +50°С и выше и хорошо проглаживать утюгом.
- Проводить дезинфекцию поверхностей в доме хотя бы раз в день.
Продолжительность выполнения данных процедур зависит только от продолжительности жизни острицы в теле человека. Как правило, весь цикл длится не дольше 40-50 дней. Если в доме есть незараженные маленькие дети, то лучше отправить их к родственникам, так как энтеробиоз у таких малышей способен вызывать массу неприятных последствий и осложнений.
Чем опасны паразиты?
Несмотря на простоту и частоту заражения, энтеробиоз является одним из наименее опасных для жизни и здоровья человека заболеваний. Лечить энтеробиоз достаточно просто. Специально для этого разработаны специальные таблетки и другие формы медикаментозных средств, которые помогают избавиться от недуга за считанные дни.
Сложнее всего избавиться от энтеробиоза у детей, так как они не всегда в состоянии самостоятельно следить за собственной гигиеной, а родитель уследить за всеми действиями ребенка тоже не может. Все же тяжелые случаи могут быть и у взрослых, когда инвазия достигла колоссальных масштабов и в теле человека проживает более 1000 взрослых особей. В связи с такой запущенностью своего здоровья может возникнуть масса проблем.
Прежде всего, это воспалительные процессы в кишечнике, вызванные физическими повреждениями слизистой оболочки органа. Впоследствии этого возникает дисбактериоз, колит и другие проблемы ЖКТ. Эти проблемы влекут за собой снижение иммунитета.

Энтеробиоз у детей как следствие пренебрежения личной гигиеной
Когда женщины не соблюдают правила интимной гигиены, то гельминты постепенно переходят во влагалище, благодаря чему развивается такое заболевание, как вульвовагинит. Нередко острицы поселяются в аппендиксе, благодаря чему человек подвержен обострению аппендицита.
Интенсивный анальный зуд может стать причиной многочисленных анальных трещин, воспаления геморроя, а также других проблем, которые усложняют стул. Избавиться от всех этих проблем помогут специальные препараты, которые обычно выписываются специалистами.
Как вылечить энтеробиоз у взрослых медикаментозными препаратами?
Заражение острицами — это тот редкий случай, когда избавиться от них можно даже не прибегая к медикаментозному лечению. Все же большинство специалистов рекомендуют не ждать и приступать к процедуре лечения сразу после обнаружения данной проблемы.
В таком случае помогают специальные таблетки, которые за считанные дни избавят вас от назойливых паразитов. Специалисты утверждают, что для выведения таких глистов можно применять любой препарат, разработанный на основе альбендазола или мебендазола.
Наиболее распространенным средством для борьбы с острицами являются таблетки Пирантел. Для самых маленьких пациентов данный препарат выпускается в форме суспензии. Применять препарат можно пациентам, достигшим возраста 6 месяцев, поэтому, покупая именно Пирантел, можно избавить от глистов всю семью сразу. Единственным недостатком таблеток является то, что употреблять их нельзя беременным женщинам и кормящим матерям. Перед глотанием таблетки рекомендуется ее предварительно разжевать.
Не менее эффективными в борьбе с энтеробиозом являются таблетки Пиперазин. Лечение данным средством предполагает пятидневный курс. В сутки человек должен получать определенное количество вещества, которое делится на 3 приема. Спустя неделю после лечения этот же курс следует пройти повторно. Среди противопоказаний производитель указывает: проблемы с нервной системой, беременность, период кормления грудью, возраст до 3 лет.

Вермокс
Достаточно активными против остриц являются таблетки или суспензия Вормил. Курс лечения должен длиться от 3 до 5 дней в зависимости от масштаба заражения. Вормил не рекомендуется применять детям до 2 лет, беременным и кормящим грудью матерям.
Среди наиболее эффективных средств можно назвать также Вермокс. Выпускается препарат исключительно в форме таблеток. Разрешается применять людям, достигшим 3-летнего возраста. Не рекомендуется использовать пациентам с серьезными проблемами ЖКТ, беременным женщинам и в период лактации, при проблемах с печенью, кроме того, при недостаче в организме лактозы. Всего 1-ой таблетки достаточно для избавления от гельминтов данного вида.
Существуют и другие средства для борьбы с острицами, которые выпускаются в разных формах. Все же наиболее эффективные и безвредные представлены выше.
Народные средства для борьбы с острицами
Подбирая метод лечения энтеробиоза, свое внимание следует сосредоточить на достаточно популярных и в то же время эффективных народных методах. Среди таких можно назвать использование цинковой мази.
Самка острицы для продолжения рода должна покинуть тело человека. Если избавить ее от такой возможности, то жизненный цикл паразитов сразу же прервется. Главную роль барьера может выполнять тампон, хорошо пропитанный в цинковой мази. Этот тампон следует ввести в анальное отверстие на ночь. Самки при этом умирают, а новые яйца просто не вызревают. Через месяц начинается период самоизлечения.
Не менее действенной является содовая клизма. Профессор Неумывакин называет данный способ борьбы не лечением, а физическим принудительным удалением из кишечника глистов, в нашем случае остриц. Стоит подметить, что таким способом полностью избавиться от паразита практически невозможно. Все же удается уменьшить количество взрослых особей. Содовый раствор приготовить достаточно просто. В стакане подогретой до комнатной температуры воды следует растворить 0,5 ч. л. соды. Жидкость следует хорошо остудить и ввести перед сном.
Избавляться от гельминтов разных видов, в том числе и от остриц, специалисты советуют тыквенными семечками. Для достижения наилучшего результата рекомендуется съедать как минимум 100 семечек. Ну а в качестве профилактики достаточно будет всего 4-6 семечек в день. При всем этом обязательно следует сохранить для съедения и верхнюю зеленую кожицу.
Неплохо в качестве профилактических мер влияют на паразитов морковный сок и чеснок. Все же полностью избавить от энтеробиоза они не могут.

Отзывы и комментарии